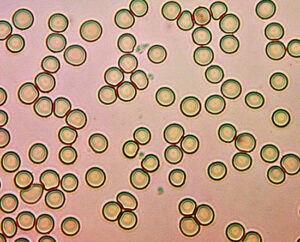

Blood Creation, Blood Destruction and, Another Window
Clifford E Carnicom
Sep 28 2025

Synthetic Biology (CDB) Crystal Development
This paper will cover a lot of territory in short form; to simplify presentation, there will be ample images. The objective here is to let it be known that methods of discovery and study that required years (if not decades) to accomplish can now, in several important respects, reach those same achievements in a matter of days. The primary catalyst here is the gain that derives from electromagnetic culturing.
One of the many benefits of past work is to know what to look for, and to identify replication. The contemporary work is not necessarilya replacement of methods, but it is one very fast confirmation and extension of them.
One topic of study is, of course, the source for change to the blood that takes place. That source is SYNTHETIC BIOLOGY (CDB). Another topic, new on the public front but often active in the background, is the study of urine. Both blood and urine can now be said to be of equal standing in the window toward understanding the extent of harm in place. Urine has the distinct advantage of being readily abundant and accessible.
Let’s list the topics, and then cover the salient points for each with an emphasis upon imagery. The presentation will be divided into those for blood and then those for urine; at the finale we should realize that there is far more overlap than difference.
Blood:
1. Coagulation vs Synthetic Biology (CDB) Density – Clear Correspondence
2. Destroy Blood
3. Create Blood
Urine:
1. Incubation with electromagnetics
2. Many complex structures and formations:
a. Synthetic Biology (CDB) alignment and grid (also within control – less developed)
b. Vertical stratification – charge indication (also within control)
c. Synthetic erythrocytes
d. Filament existence – Filament potential (also within control)
e. Synthetic Biology (CDB) progression into synthetic RBC
f. Iron oxide proteins (also within control)
g. Sophisticated crystal biology – uric acid crystals insufficient
h. Linear formation of CDB (dominant in control)
I would suppose this is the place to stop if you would only like the abstract (but in that case you would miss the photos…). Others, please carry on and I thank you.
_____________________
Blood:
Here we go, starting with blood:
1. Coagulation vs Synthetic Biology (CDB) Density – Clear Correspondence
It can be stated that the degree of coagulation in blood via microscopy is a direct result and outcome of infusion of the synthetic biology (CDB) into the blood. The paper titled, The Source of Blood Coagulation: Cross Domain Bacteria (CDB) (Aug 2024) remains valid. This does not deny or dismiss the influence of other factors (such as the COVID era). However, as discussed extensively (Vaxxed vs. Unvaxxed : Blood Differences Identified, May 2024), these appear to be compounding layers of an already existing situation, now dating back close to three decades.
In addition to the previous references, time to get the photos started:
Reference red blood cells.
No significant synthetic biology (CDB) presence.
Red blood cells remain generally free standing and of uniform geometry.
Original magnification approx. 3200x

Significant, but relatively moderate synthetic biology (CDB)
infusion into red blood cells.
(CDB are sub-micron structures WITHIN the blood cells)
Red blood cells remain relatively free standing and uncoagulated.
Original magnification approx. 3200x

Serious synthetic biology (CDB) infusion into red blood cells.
(CDB are sub-micron structures WITHIN the blood cells)
Red blood cells show significant aggregation and moderate deformation.
Original magnification approx. 3200x

Severe synthetic biology (CDB) infusion into red blood cells.
(CDB are sub-micron structures WITHIN the blood cells)
Red blood cells show high level aggregation and increased cell deformation.
Original magnification approx. 3200x
2. Blood Destruction
The synthetic biology (CDB), if severe and sustained, has the clear capability to destroy the ability of the blood to function normally.

Serious infusion level of synthetic biology (CDB) within the blood.
Questionability of the cell to function at any meaningful level in this state.
Original magnification approx. 7000x.
Blood damage documented in:
And Now Our Children, Jan 2008

Serious infusion level of synthetic biology (CDB) within the blood.
Questionability of the cell to function at any meaningful level in this state.
Original magnification approx. 7000x.
Blood damage documented in:
A Mechanism of Blood Damage, Dec 2009

Drastic infusion level of and damage from synthetic biology (CDB) within the blood.
Massive deformation of cell integrity and geometry.
Unlikely that the cell can function in this state.
Original magnification approx. 3200x.
Blood damage documented in: THIS PAPER
3. Create blood
The synthetic biology (CDB) has the ability, by all means of study over extended time, to create a synthetic form of blood. This is true, regardless of the shock quotient that is reasonably justified. The literature, however, is replete with such ambitions and accomplishments, and the history of this site testifies to it as well. Multiple tests (chemical and titration) herein have confirmed the existence of hemoglobin.
And thus we have, within a single synthetic biological entity, that has the ability to both create “blood” and destroy BLOOD. Quite the paradox.
One may start by looking at the record that has already been established in this site alone. You may explore the ‘ambition’ further with the literature. As far as this site goes, we begin in 2009 :
Blood Issues Intensify, Apr 2009.
Artificial Blood, Aug 2009.
Cross Domain Bacteria (CDB) : Synthetic Blood & Hemoglobin, Nov 2023.
4. Synthetic Blood (in addition to immediately prior references):
What distinguishes this study is the use of urine for the sample. The urine is a sample that is known to contain significant quantities of the synthetic biology (CDB). What further distinguishes this study is the application of a Very Low Frequency (VLF) to the sample for a period of several days. Urine is our new window on the block here.
What is observed is that the synthetic biology (CDB) takes on extremely ordered arrangements within the sample, leading to a cellular progression that is astounding in all respects. This is primarily the create and destroy paradox. That which is known to be able to obliterate red blood cell and function is also observed to develop in all known respects to a fully formed red “blood” cell, albeit it entirely from a synthetic biological origin. The observations, along with previous work as unusual as they may seem, provide the redundant conclusions. Geometry (circular, biconcave) and size (i.e., 6-8 microns upon full development) match with expectations of red cell formation, and previous positive hemoglobin and titration tests are critical additional factors to justify the certainty.
The final developed cell form has been viewed hundreds of times over the years; what differs here is a specific progression that has been captured from CDB polymorphic development.
It is difficult to reach any other conclusion than that of a transformative process in place upon human biology. You may also wish to consider the following papers:
The Transformation of a Species?, Nov 2019.
Human Transformation : Synthetic Blood, Bioplastics, and the Global Blood Clot, Nov 2023.

Synthetic Blood Development Progression
in Urine Electromagnetic Culture
Source of development is the synthetic biology (CDB)
Maximum cell size (6-8 microns), biconcavity and geometry
matches that of human erythrocytes.
Original magnification approx. 3200x.
Black(1): Earlier stage of development
Cyan(2) : Mid-level development
Red(3): Final representative development
Extensive CDB growth at various focal planes
surrounds the capture of this progression.
Original magnification approx. 3200x.

Second Example:
Synthetic Blood Development Progression
in Urine Electromagnetic Culture
Source of development is the synthetic biology (CDB)
Maximum cell size (6-8 microns), biconcavity and geometry
matches that of human erythrocytes.
Original magnification approx. 3200x.
Black(1): Earlier stage of development
Cyan(2) : Mid-level development
Red(3): Final representative development
Extensive CDB growth at various focal planes
surrounds the capture of this progression.
Original magnification approx. 3200x.
5. Sophisticated Crystal Biology
Here we have a repeat phenomenon, but different in a very important way. The crystal biology witnessed prior was primarily a singular result, one of the many variations that result from PHYSICAL MEDIA culture methods that have been developed. Culturing has the fundamental importance of being able to replicate the growth and metabolism in a controlled environment, which remains crucial to any further serious research.
The emergence of the identical remarkable crystal biological forms here is the result of the electromagnetic culturing under development. The first method can require weeks to months to develop crystal forms. The recent method required four days. Even more crucial to any further serious research, as our time ahead is hardly infinite.
Your preview to the issue is here, understanding that lengthy and specific physical culturing (weeks to months duration) was required:
Cross Domain Bacteria (CDB) Protein : Exotic Crystal Biology, Sep 2023.
Laboratory note photographs that complement the above paper were taken and collected on Sep 26 2023, one of which follows:

Synthetic biology (CDB) exotic biological crystal developed
through physical culturing Sep 2023.
Original magnification approx. 3200x.
Two years later the same accomplishment is achieved using an electromagnetically developed urine culture over a period of four days vs. weeks of physical culture development:

Synthetic Biology Crystal Development
via VLF Electromagnetic Culture Method
CBD Representative Filament-Biological Growth Encased within Crystal
Timespan 4 Days vs. Weeks for Physical Culture
Original Magnification approx. 3200x.

Synthetic Biology Crystal Development
via VLF Electromagnetic Culture Method
CBD Representative Filament-Biological Growth Encased within Crystal
Timespan 4 Days vs. Weeks for Physical Culture
Original Magnification approx. 3200x.

Synthetic Biology Crystal Development
via VLF Electromagnetic Culture Method
CBD Representative Filament-Biological Growth Encased within Crystal
Timespan 4 Days vs. Weeks for Physical Culture
Original Magnification approx. 3200x.
6. Grid, Stratification, and Charge Behavior of Synthetic Biology (CDB)
This is another interesting case. More than interesting, of course. The phenomenon appears both in VLF electromagnetic culture and non-electromagnetic incubation only trials (ambient ELF fields, however, remain). It does, however, appear to be more pronounced, developed, and sophisticated within the electromagnetic cultured version.
The phenomenon appears to involve three factors at play;
- Grid formation
- Stratification in the vertical plane
- Suspected charge mechanisms to induce the separation
In these photographs, the focus is deliberately and slightly skewed to improve visibility of the phenomenon. Each small circular entity (approx. 0.5 microns) corresponds primarily to the synthetic biology (CDB) form.
What is occurring here is a view on the underside of the cover slip. One might be inclined to interpret a slide liquid artifact here (even that would be difficult), but this does not prove to be the case. The phenomenon remains as the slide is dry. A proposed mechanism here involves a charge separation and charge organization within a network scenario. The grids formed are not always perpendicular and can be single axis as shown; furthermore skew angles can develop but the grid nevertheless remains with a level of parallel and uniform spacing. The core unit of the grid development is the synthetic biology (CDB).
Overall, several different subtle focal planes with the sample on a glass slide with cover slip are used to capture the various phenomena shown.

Right angle synthetic biology grid development
occurring within urine electromagnetic culture.
Core structural unit of the grid is the synthetic biology (CDB)
Examples are circled in red.
Time of development approx. 3 days.
Original magnification approx. 3200x.

Single axis synthetic biology grid development
occurring within urine electromagnetic culture.
Core structural unit of the grid is the synthetic biology (CDB)
Examples are circled in red.
Time of development approx. 3 days.
Original magnification approx. 3200x.

Parallel bounded synthetic biology grid development
occurring within urine culture (ambient ELF only).
Core structural unit of the grid is the synthetic biology (CDB)
Examples are circled in red.
Time of development approx. 3 days.
Possible precursor to filament production.
Original magnification approx. 3200x.
7. Linear Formation of Synthetic Biology Core Unit (CDB)
This sample is the control urine sample that is subject to ambient ELF only. The phenomenon has been recorded prior, but not in such flagrant and obvious detail. This represents another of the many forms of growth the synthetic biology (CDB) can take. The first evidence of this form was in the following paper and it established a realistic basis upon how the synthetic biology filament develops.
CDB : Growth Progressions, Jun 2014.
There are those who interpreted the filaments as ‘spawning’ the growth of the CDB, but the observational evidence has never borne that out. This is a clear example of, once again, the case of the CDB being the origin of all subsequent growth patterns observed and known.

Synthetic Biology (CDB) linear collocation.
Historically interpreted as the precursor to filament production.
Original magnification approx. 3200x.

Synthetic Biology (CDB) linear collocation.
Black arrows point to magnified examples.
Historically interpreted as the precursor to filament production.
Original magnification approx. 3200x.

Synthetic Biology (CDB) linear collocation.
Further magnification of a chain segment (red).
Core unit of construction is the synthetic biology (CDB).
Historically interpreted as the precursor to filament production.
Original magnification approx. 3200x.
8. Filaments and Iron Oxide Protein Formation
These phenomenon are commonly recorded over the years and do not have special bearing to the electromagnetic culturing method. A couple of representative photos are provided for reference, and the topics have been discussed in some detail prior. These photos can be associated with both urine samples, the VLF sample and the control sample subject only to ambient electromagnetic fields.
Synthetic biology (CDB) granular iron-oxide protein formation.
Original magnification approx. 3200x.

Synthetic biology (CDB) granular iron-oxide protein formation.
Original magnification approx. 3200x.

Representative filament of the synthetic biology (CDB)
Complex biological growth in the interior,
permeated with CDB linear collocation-interior filament growth.
This filament from the incubated urine sample – ambient electromagnetic fields only.
Original magnification approx. 3200x.
Please be aware that polymer formation, as demonstrated within the physical culture methods, is not a product of the electromagnetic culturing techniques at this time. Up to six months of time was required to produce the mature forms of the polymers via physical culturing.
The objective of this paper is to present many of the advantages that have arisen from the development of electromagnetic culturing techniques for the synthetic biology (CDB). This includes the important factors of time reduction by numerous orders of magnitude, as well as additional insight into the many complex forms the CDB is capable of producing. The paradox development of blood creation and blood destruction is also especially important. The rapid turnover rate for culture examination provides insight into the numerous biological, crystalline, protein forms and blood transformations that occur simultaneously.
With my best regards,
Clifford E Carnicom
Sep 28 2025
born Clifford Bruce Stewart
Jan 19 1953
_____________________

Synthetic Biology Skin Affliction (CDB)
(Time span: 4 years)
(Popular terminology: Morgellons)

Managed Synthetic Biology Skin Affliction (CDB)
(Time span: approx. 2 months)
June 2024:
An Invitation
An Invitation

